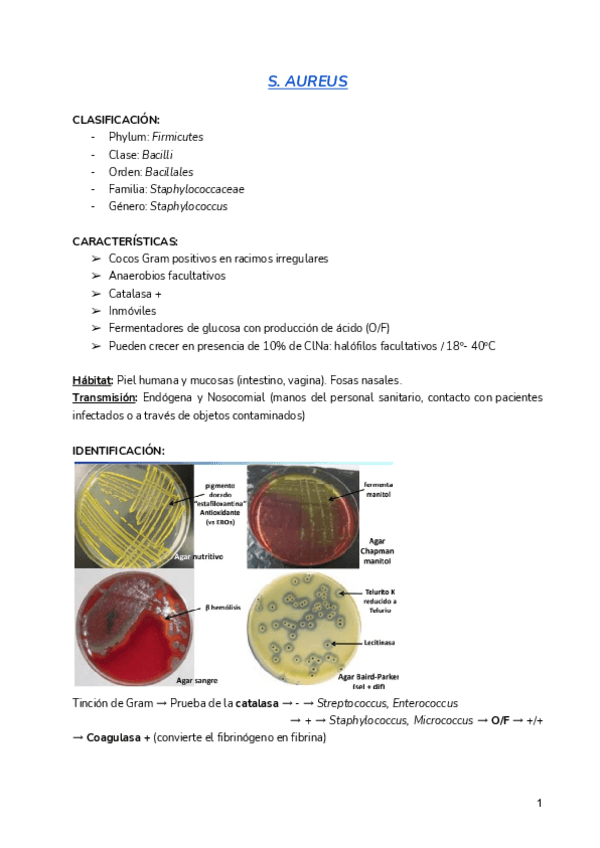

2-La-Diversidad-de-los-Microorganismos.pdf
6 páginas

3-Microscopia-y-Observacion-de-Microorganismos.pdf
3 páginas

5-La-Pared-Celular.pdf
7 páginas

8-Nutricion-y-Metabolismo-Microbianos.pdf
18 páginas

9-Crecimiento-y-Cultivo-Microbianos.pdf
25 páginas

10-Estructura-Morfologia-y-Taxonomia-de-los-Virus.pdf
5 páginas

11-Multiplicacion-de-los-Virus.pdf
16 páginas

12-Genomica-Microbiana.pdf
10 páginas

13-Variabilidad-Genetica-en-Microorganismos-Mutacion.pdf
4 páginas

14-Variabilidad-Genetica-en-Microorganismos-Recombinacion.pdf
5 páginas

15-Transmision-Horizontal-de-Informacion-Genetica.pdf
9 páginas

16-Modificacion-Genetica-de-Microorganismos.pdf
6 páginas

4-La-Membrana-Citoplasmatica.pdf
7 páginas

6-Capsulas-y-Estructuras-de-Superficie.pdf
5 páginas

7-Esporas-Microbianas.pdf
4 páginas

17-Taxonomia-Bacteriana.pdf
5 páginas

18-Taxonomia-de-Hongos-Microscopicos.pdf
5 páginas

28-Conceptos-de-Ecologia-Microbiana.pdf
2 páginas

29-Microbiologia-del-Suelo-y-Agua.pdf
5 páginas

19-Control-del-crecimiento-microbiano.pdf
2 páginas

20-Higienizacion-Desinfeccion-Antisepsia-y-Esterilizacion.pdf
14 páginas

21-Antibiosis.pdf
6 páginas

22-Resistencia-a-Antibioticos.pdf
6 páginas

23-Antibioticos-que-Actuan-sobre-la-Pared-Celular-y-la-Membrana.pdf
14 páginas

24-Inhibidores-de-la-Sintesis-Proteica.pdf
9 páginas

25-Inhibidores-de-la-Sintesis-y-Metabolismo-de-Acidos-Nucleicos.pdf
6 páginas

26-Antifungicos.pdf
8 páginas

27-Antiviricos.pdf
7 páginas

30-El-Ser-Humano-como-Nicho-Ecologico.pdf
7 páginas

31-Interaccion-entre-Hospedador-y-Patogeno.pdf
15 páginas

32-Inmunizacion.pdf
8 páginas

33-Microbiologia-Industrial.pdf
5 páginas

34-Busqueda-Aislamiento-e-Identificacion-de-Microorganismos.pdf
5 páginas

35-Tecnologia-de-las-Fermentaciones-Industriales.pdf
7 páginas

36-Produccion-Microbiana-de-Farmacos.pdf
5 páginas

37-Microbiologia-de-las-Aguas.pdf
11 páginas

38-Microbiologia-de-los-Alimentos.pdf
7 páginas
S.pdf
4 páginas

E.pdf
5 páginas

C.pdf
5 páginas

Herpesvirus.pdf
4 páginas

M.pdf
2 páginas